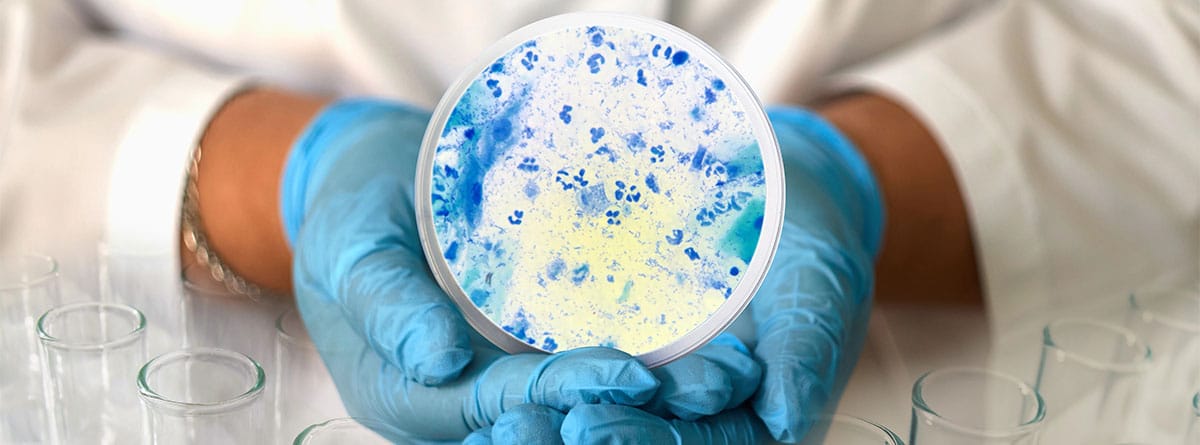

Descubre la Enfermedad de la Carne: Triquinosis
Todo sobre la Triquinosis: Enfermedad Parasitaria Transmitida por Consumir Carne Contaminada
La triquinosis, también conocida como triquinelosis, es una infección parasitaria provocada por las larvas del nematodo Trichinella. Esta enfermedad se transmite principalmente al ingerir carne cruda o insuficientemente cocida que contiene larvas de este parásito. Es fundamental comprender los riesgos asociados con esta infección y la importancia de un diagnóstico temprano y un tratamiento oportuno para prevenir complicaciones graves.
Síntomas y Diagnóstico de la Triquinosis
Los síntomas de la triquinosis pueden variar desde leves hasta graves, e incluyen dolor abdominal, fiebre, inflamación de párpados, debilidad muscular y otros problemas gastrointestinales. Es fundamental buscar atención médica si se sospecha de esta infección, ya que un diagnóstico precoz es clave para un tratamiento efectivo.
Diagnóstico
El diagnóstico de la triquinosis se basa en la historia clínica del paciente, los síntomas presentados y pruebas específicas para detectar la presencia de larvas de Trichinella en muestras de tejido muscular. Es importante informar al médico sobre posibles exposiciones a carne cruda o poco cocida para facilitar el diagnóstico adecuado.
Tratamiento y Prevención de la Triquinosis
El tratamiento de la triquinosis generalmente implica el uso de medicamentos antiparasitarios para eliminar las larvas de Trichinella del cuerpo. Es fundamental seguir las indicaciones médicas y completar el tratamiento para garantizar la erradicación completa del parásito y prevenir recaídas.
Prevención
Para prevenir la triquinosis, es fundamental seguir prácticas adecuadas de higiene alimentaria, como cocinar la carne a temperaturas seguras para destruir cualquier posible contaminación por larvas de Trichinella. Evitar el consumo de carne cruda o poco cocida, especialmente de cerdo o animales salvajes, es clave para reducir el riesgo de contraer esta enfermedad parasitaria.
Importancia de la Higiene Alimentaria en la Prevención de Enfermedades Parasitarias
La triquinosis es solo una de las muchas enfermedades parasitarias transmitidas a través de alimentos contaminados. Mantener una adecuada higiene alimentaria, desde la manipulación hasta la cocción de los alimentos, es esencial para prevenir infecciones parasitarias y proteger la salud de toda la familia.
Recomendaciones
- Cocinar la carne a temperaturas seguras, especialmente la de cerdo y animales salvajes.
- Evitar el consumo de carne cruda o poco cocida en establecimientos no regulados.
- Lavarse las manos y utensilios de cocina con regularidad para prevenir la contaminación cruzada.
Conclusión
En resumen, la triquinosis es una enfermedad parasitaria seria que puede prevenirse con medidas adecuadas de higiene alimentaria y un consumo responsable de carne. La educación sobre los riesgos asociados con esta infección es fundamental para evitar su propagación y proteger la salud de la población. Ante cualquier síntoma sospechoso, es crucial buscar atención médica para un diagnóstico y tratamiento oportunos.